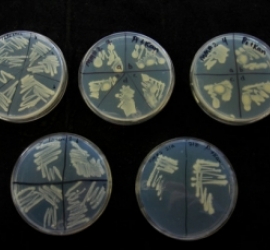

Perú: Defensoría denuncia poca atención para indígenas
Eduardo Vega, Defensor del Pueblo exhortó a la titular del Ministerio de Salud (Minsa), Midori de Habich, a destinar mayores recursos económicos e incrementar el número de personal para brindar una mejor atención de salud a las poblaciones indígenas. “Se requiere que los establecimientos de...
Read more